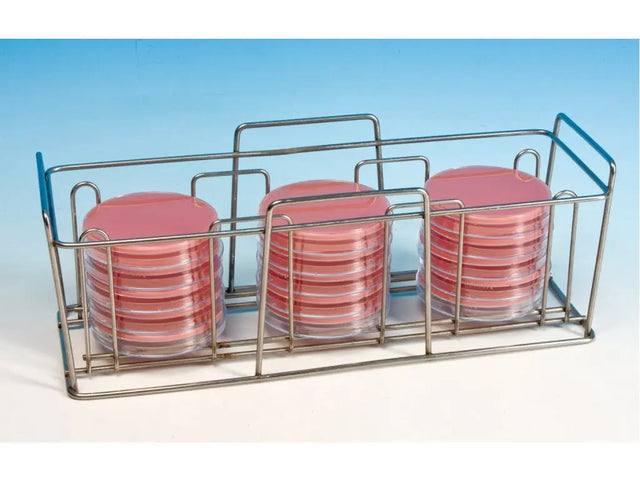

Laboratoires Humeau | SKU:
213021
Petrischaal rek RVS v. 18 schalen 90 mm
Reguliere prijs
€100,96
Eenheid prijs
Verpakkingseenheid:
1
Waarom bestellen bij Antonides?
✅Persoonlijk en betrouwbaar
✅Flexibel en op maat
Petrischaal Rek RVS
Geschikt voor 18 Petrischalen van 90 mm ( 3*6 )
370 X 135 X H 130 mm
Geschikt voor 18 Petrischalen van 90 mm ( 3*6 )
370 X 135 X H 130 mm
-
Merk
-
Merk artikelnummer
Afbeeldingen dienen ter illustratie. Product kan afwijken van de getoonde foto.